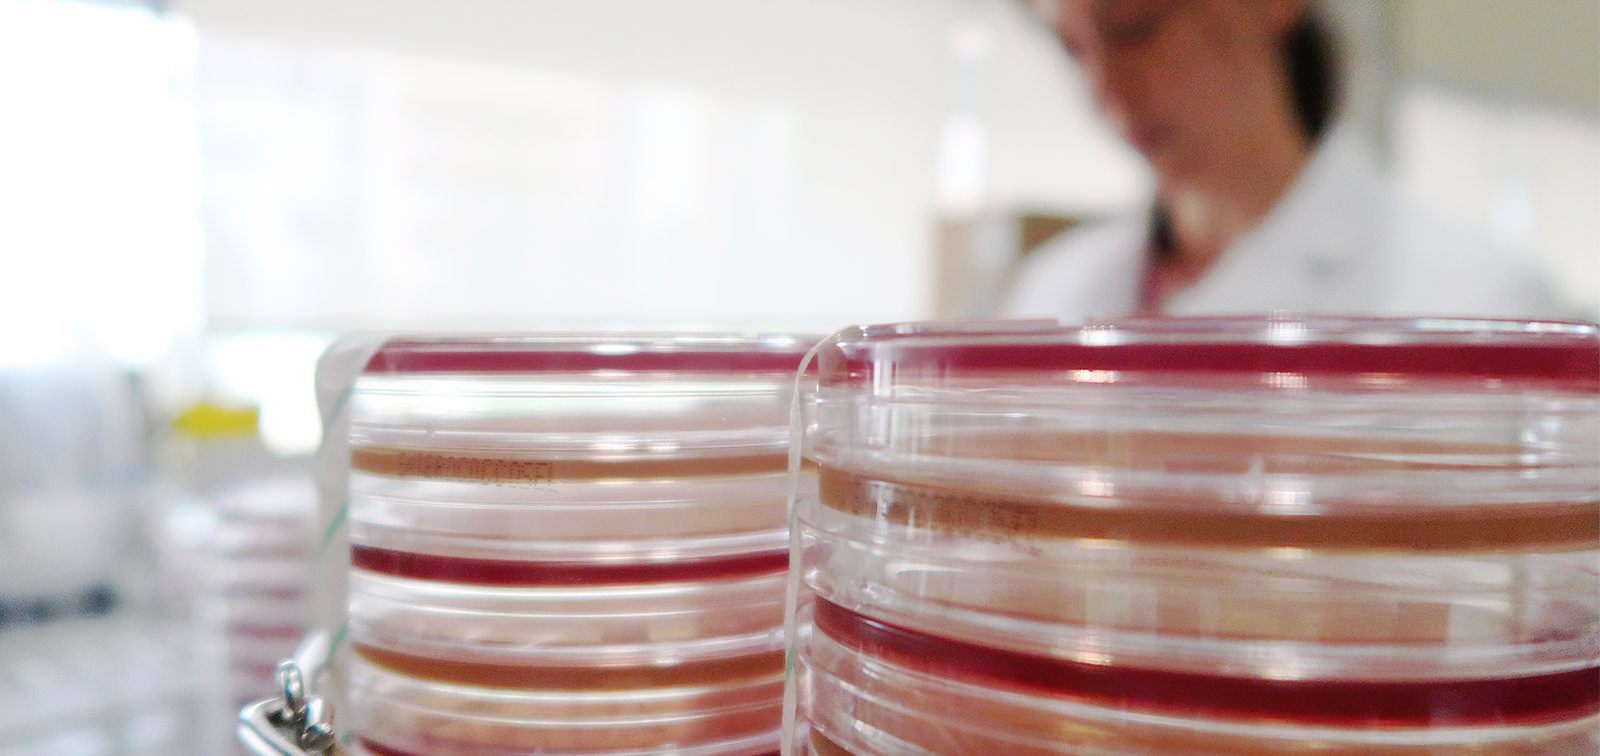
PreFIT Project

2G Color Plates
2nd Generation Color Agar Plates to Diagnose MDR-Tuberculosis: a Prospective Pilot Study
- Duration
- 2020 - 2022
- Coordinator
- Alberto García-Basteiro
- Funded by
- National Institutes of Health (NIH)
Tuberculosis (TB) is now the leading infectious disease cause of death worldwide, killing one person every 21 seconds. The growing burden of detected rifampicin-resistant (RR) and multidrug-resistant (MDR)-TB is hindering TB prevention, surveillance and care.
Extensively drug resistant (XDR)-TB is a severe form of MDR-TB that involves MDR M. tuberculosis (Mtb) strains that are additionally resistant to any fluoroquinolone (FQ) and a second-line injectable drug (kanamycin, amikacin, or capreomycin) (2) Mtb strains causing extreme drug resistant (XXDR)-TB are resistant to all 1st and 2nd line TB drugs (1,2). Currently, a person with drug resistant TB goes into a short drug regimen with 7 drugs on a daily basis for 9 months, regardless of age or HIV status (3).
Under programmatic conditions in endemic countries, sputum is collected and cultured every month after drug resistant TB treatment initiation, to further perform the drug susceptibility test to determine if the patient is responding or not to the treatment. In many endemic areas where line probe assays are not available (urban and rural), this process might take between 42-60 days (1).
We propose to use an agar-layer based platform that can shorten this period to a maximum of 14 days. Although our agar-layer test is not a molecular based assay as some of the PCR-based instruments currently being used to diagnose drug susceptible and rifampicin resistant TB, our test can diagnose phenotypic resistance for 11 TB drugs, thus making it unique for this purpose.
This novel test is designed to be a relatively fast, easy-to-use, and inexpensive drug susceptibility testing (DST) for drug-resistant TB in high TB incidence areas. This 2G Color Plate test could be useful for early TB resistance detection in MDR-TB individuals, and importantly, for treatment monitoring. We will compare the performance of this test against Xpert MTB/RIF Ultra, Line probe assays (LPA) and BACTEC MGIT drug susceptibility testing (DST).
Objectives
- Objective 1. To evaluate the accuracy of the 2G Color Plate in diagnosing drug resistant TB.
- Objective 2. Assess the usefulness and turn around time of the 2G Color Plate in monitoring if a patient infected with drug resistant TB is responding to the treatment.
In Objective 1, sputum will be collected from 110 pulmonary TB patients, 60 rifampicin susceptible (RS) and 50 rifampicin resistant (RR) according to Xpert MTB/RIF Ultra testing performed prior treatment initiation. We will determine the sensitivity and specificity, and the turnaround time of the results provided by the 2G Color plate for detection of drug resistance (using BACTEC MGIT DST as gold standard). We will also compare these diagnostic performance indicators to those of LPA. We will also estimate sensitivity for 2G Color Plate for detection of M tuberculosis (gold standard: BACTEC MGIT)
In Objective 2, sputum samples will be collected from 50 RR (RR TB patients identified in Aim 1) and 60 RS pulmonary TB patients currently under drug-resistant TB therapy to monitor if these TB patients are responding to their treatment, and compare our results with BACTEC MGIT based DST. We will conduct testing during the first year of treatment, as per national guidelines.
Partners
- Centro de Investigação em Saúde de Manhiça (CISM)
- Barcelona Institute for Global Health (ISGlobal)
- Texas Biomedical Research Institute
Duration
The estimated duration of the study will be 2 years (2020-2022) from the time the first participant signs the informed consent until the last participant completes a 6-month follow-up period.
Funding
NIH funded study
Overall Grant Awarded: 214,920 USD
Contact
Our Team
Coordinator
-
Alberto García-Basteiro
ISGlobal Team
-
Belén Saavedra Cervera
Other projects
INCENTIVE
Indo-European Consortium for Next Generation Influenza Vaccine Innovation
Global Metabolic Health Roundtable Series
Addressing the Public Health Threat of MASLD/MASH and other major NCDs
Evaluación de la eficacia del ácido acetilsalicílico a dosis bajas en la prevención de los efectos maternos y perinatales adversos en mujeres embarazadas infectadas por el SARS-CoV-2
FLAVOBAC
Nuevas moléculas de oro coordinadas con flavonoides contra bacterias patógenas multirresistentes prioritarias
EpiGen
Building Scalable Pathogen Genomic Epidemiology in Ethiopia
ENDÈMIC
Community knowledge generation through scientific culture, urban ecology and art
Más allá de la supresión vírica del VIH: un cuarto noventa para mejorar la salud de personas viviendo con el VIH en España
Project Code: PI20/01654